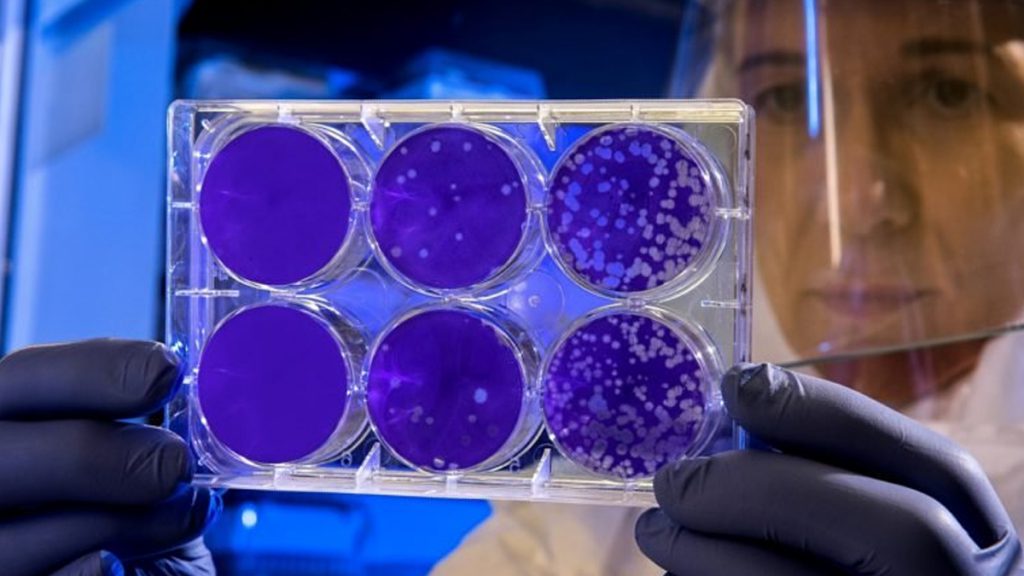

El estudio explica que cuando el agente viral penetra en la célula se pone en marcha un inhibidor del ‘sensor’ responsable de advertir de la presencia de ADN extraño en la célula, lo que impide que se active una respuesta inmune eficaz.
forbes.com.mx
Un equipo de investigadores ha identificado el mecanismo por el que una familia de virus, los poxvirus, son capaces de evadir la activación temprana de la repuesta inmune durante una infección, según un estudio que publica Science Advances.
El estudio, liderado por miembros del Consejo Superior de Investigaciones Científicas (CSIC), el mayor centro de investigación español, explica que cuando el agente viral penetra en la célula se pone en marcha un inhibidor del ‘sensor’ responsable de advertir de la presencia de ADN extraño en la célula, lo que impide que se active una respuesta inmune eficaz por parte del huésped.
Los científicos esperan usar este sistema para modular las reacciones inflamatorias excesivas provocadas por afecciones autoinmunes como la artritis reumatoide, el lupus eritematoso sistémico o la esclerosis múltiple, según el CSIC.
La investigación se centró en analizar un modelo de infección llamado mousepox, que provoca en los ratones una patología semejante a la viruela, una de las enfermedades infecciosas más virulentas a las que se ha enfrentado el ser humano, y en la actualidad ya erradicada.
Durante la infección, el virus que causa la mousepox libera una proteína llamada Schlafen, cuya función es inhibir el mecanismo de detección de ADN en el citoplasma de las células infectadas.
Sin embargo, si el virus se modifica genéticamente para que no produzca el inhibidor Schlafen, los ratones sobreviven a la enfermedad.
“Los mecanismos de detección con sensores de ADN resultan cruciales para elaborar una respuesta capaz de contener al virus. Una defensa exitosa frente a las infecciones virales se basa en el temprano reconocimiento de este tipo de patrones asociados a estos patógenos que delatan su presencia y desencadenan una temprana respuesta de nuestro organismo”, explica Bruno Hernáez, del Centro de Biología Molecular Severo Ochoa (CBM-CSIC-UAM).
Los resultados de estudio, El estudio, realizado en colaboración con Carlos Maluquer de la Universidad de Surrey (Reino Unido), van más allá de la respuesta inmune frente a virus como posible estrategia terapéutica para tratar enfermedades inflamatorias.
“De igual forma que los virus controlan la respuesta contra su ADN extraño, este trabajo demuestra que podemos utilizar la misma estrategia que utilizan los virus para inhibir respuestas inflamatorias excesivas que dan lugar a patologías autoinmunes”, concluye Antonio Alcamí, investigador del CBM-CSIC-UAM.